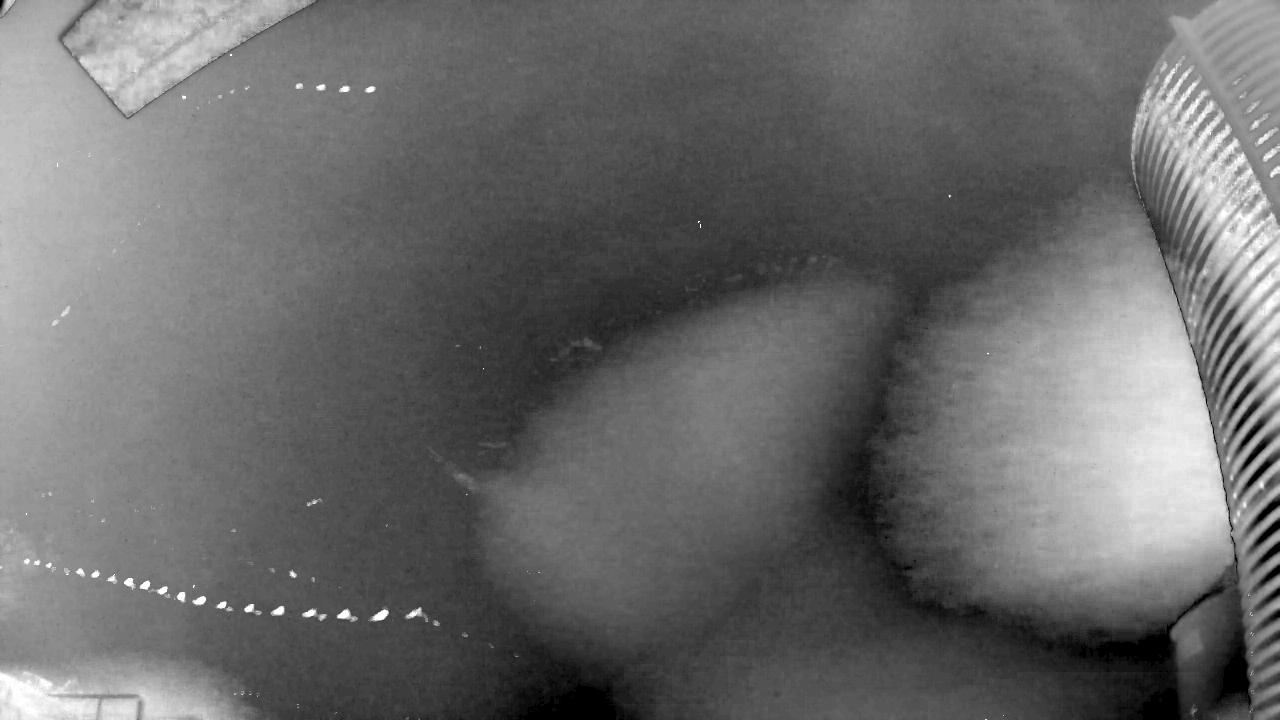

Last updated: 2025-11-13 18:41:57 UTC
NZ0044
Recording begin: 2025-11-13 08:15:34 (UTC)
Captured Stack:
Detected thumbnails:

Captured thumbnails (5 stacked per thumbnail):

FF intervals:

Deaveraged field sums:

Peak field sums:

Astrometry report:

Timelapse Video:
